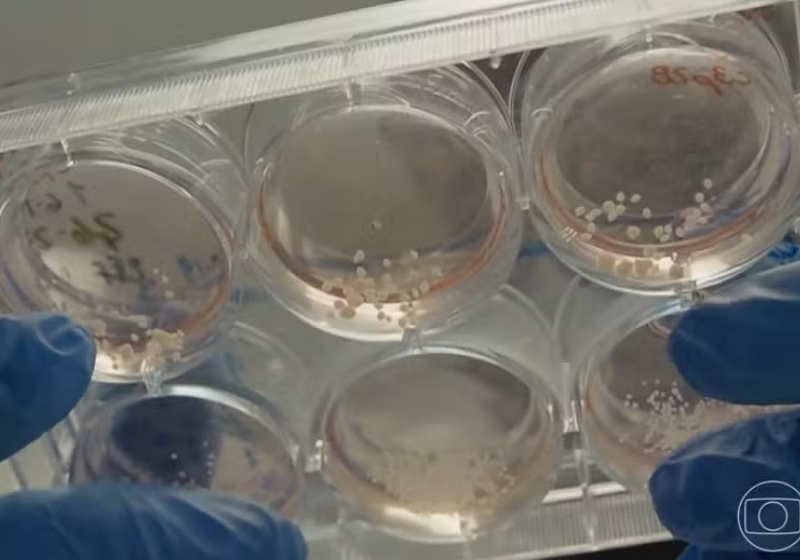
Esses são os cérebros de laboratório desenvolvidos pelo cientista brasileiro nos Estados Unidos. Foto: JN/TV Globo

Autismo: cientista brasileiro desenvolve cérebro em laboratório para pesquisar sistema nervoso

Determinado a buscar qualidade de vida para pessoas com autismo, este cientista brasileiro desenvolveu um cérebro em laboratório para pesquisar o sistema nervoso e alternativas de tratamento para várias síndromes. Ele tem um filho autista severo.
Alysson Muotri, professor na Universidade da Califórnia em San Diego, nos EUA, e sua equipe criaram minicérebros de laboratório a partir de dentes de crianças com transtorno do espectro autista (TEA). Em seguida, adicionaram medicamentos naturais e químicos. Na última etapa, enviaram o material para uma temporada no espaço.
“Eu tive meu filho Ivan, que tem um autismo profundo ou severo. Isso passou a me motivar mais ainda para acelerar as pesquisas. Eu quero realmente ajudar essas famílias a ter uma qualidade de vida melhor”, disse o professor.
Cérebro em laboratório
Alysson construiu um robozinho que está aprendendo a andar. “Quem controla é o cérebro humano criado em laboratório”, explicou.
Questionado se o cérebro humano um dia poderá ser um computador, o cientista disse que os pesquisadores trabalham nessa ideia de usar um cérebro humano criado em laboratório como um computador.
O brasileiro chama essa tecnologia de “inteligência de organoide”. “Pode eventualmente complementar ou até, em certas ocasiões, substituir a inteligência artificial como a gente tem”.
Leia mais notícia boa
- Pesquisadores descobrem como “desligar ansiedade” no cérebro; veja!
- Sabia que existem seis tipos de amor? Ativam áreas diferentes do cérebro, descobrem cientistas
- Cientistas fazem cérebro voltar a funcionar após morte; veja o motivo
Fada do Dente
O estudo envolve o projeto “Fada do Dente” em que crianças de várias parte dos EUA foram estimuladas a “doar” um dentinho para a pesquisa. Em seguida, ele foi até a Amazônia onde conversou com os sábios da região para descobrir o que “era bom para a cabeça”.
Com as informações nas mãos, o cientista apelou para os drones que logo identificaram esses medicamentos naturais, depois foi a vez de mandar parte do projeto para o espaço. É que há informações que indicam que o cérebro dos astronautas sofre muito com viagens fora da Terra.
Alysson mostrou os resultados numa palestra no Texas. “Tem uma série de medicamentos que a gente já descobriu que ajudam na melhor manutenção dessas redes neurais o cérebro humano, e diminuem os problemas até comportamentais”, disse o brasileiro ao Jornal Nacional/TV Globo.
Cérebro com Alzheimer
O cientista disse que essas drogas testadas são autorizadas nos EUA para tratar epilepsia e autismo. Agora ele quer mais: analisar um cérebro com Alzheimer. E está usando uma alternativa incrível.
“Para estudar um cérebro, por exemplo, que tem Alzheimer, eu precisaria esperar 70 ou 80 anos. Na estação especial, eu consigo chegar nesse estágio em um mês. Então, a gente usa a estação espacial como uma incubadora dos minicérebros e, quando eles voltam à Terra, eles envelheceram”.
Brasileiro de Campinas, SP
Alysson Muotri estudou biologia em Campinas e fez doutorado em Genética na Universidade de São Paulo (USP).
Depois, o brasileiro foi estudar na Universidade de Harvard e, agora, é pesquisador na Universidade da Califórnia em San Diego.
Aplausos a esse brasileiro incansável!

Novas regras do Pix vão permitir pagamento por aproximação e limites personalizados
Novas regras do Pix vão permitir pagamento por aproximação e limites personalizados Recorde da CazéTV no YouTube dispara durante a Copa e faz história na internet
Recorde da CazéTV no YouTube dispara durante a Copa e faz história na internet Servente de pedreiro e bailarino: Pedro faz cookies para participar do Festival de Joinville; vídeo
Servente de pedreiro e bailarino: Pedro faz cookies para participar do Festival de Joinville; vídeo Siamesas unidas pela cabeça são separadas por médico brasileiro em Abu Dhabi; já tiveram alta
Siamesas unidas pela cabeça são separadas por médico brasileiro em Abu Dhabi; já tiveram alta A gigante voltou: Rebeca Andrade é ouro no Pan do Rio, após 2 anos afastada por saúde mental
A gigante voltou: Rebeca Andrade é ouro no Pan do Rio, após 2 anos afastada por saúde mental Analfabetismo cai ao menor nível desde 2016 no Brasil e leva dignidade a 600 mil pessoas
Analfabetismo cai ao menor nível desde 2016 no Brasil e leva dignidade a 600 mil pessoas PM agradece ao marido gari que pegava livros do lixo para ela estudar e vencer na vida; vídeo
PM agradece ao marido gari que pegava livros do lixo para ela estudar e vencer na vida; vídeo Apostador do Rio ganhou sozinho na Mega-Sena: R$ 39 milhões para mudar de vida
Apostador do Rio ganhou sozinho na Mega-Sena: R$ 39 milhões para mudar de vida Mãe do goleiro Vozinha chega aos EUA para ver o filho brilhar na Copa e emociona torcida; vídeo
Mãe do goleiro Vozinha chega aos EUA para ver o filho brilhar na Copa e emociona torcida; vídeo Matheus Cunha: quem é o menino pobre da Paraíba que salvou o Brasil com 2 gols contra o Haiti
Matheus Cunha: quem é o menino pobre da Paraíba que salvou o Brasil com 2 gols contra o Haiti